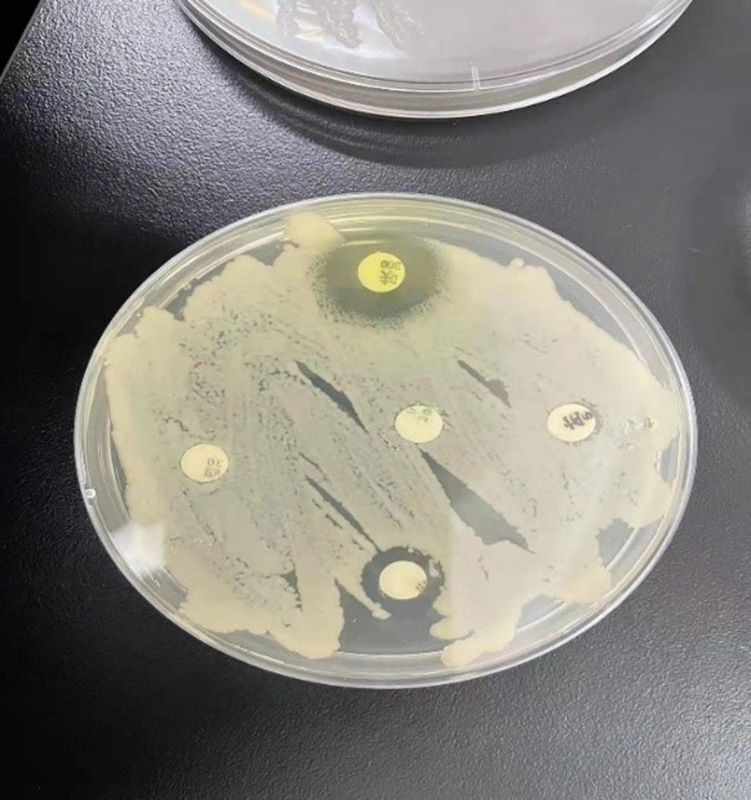

党政管理机构
教学机构
教辅机构
群团
2021-12-20 10:50
来源: 赤峰应用技术职业学院
畜牧兽医系为营造人人皆可成才、人人尽展其才的良好环境,努力让每个学生都有人生出彩的机会,从2021年12月1日起2021级动物医学、畜牧兽医、畜禽生产技术三个专业全体学生分组开展实验室检验岗位专项训练。
一、 精心策划,周密部署
专项训练开始之前陈学风主任召集相关教师一同精心策划本次专项技能训练。并对实验室检验岗位必须掌握的技能到每项技能的典型工作环节;从实验室生物安全到每一步操作注意事项;从实验器材的计划采购到实习报告的撰写评比等各项工作进行部署。
二、 突出重点,注重实效
2021年12月1日第一轮实验室检验专项训练开始拉开序幕。



本次专项训练为期17天,顺利完成了实验室检验岗位必须掌握的六大部分
内容、几十个技能点。
每个班级三天的专项训练包括
1、 细菌培养基的制备



2、 细菌的分离培养



3、 药物敏感性试验

4、 细菌涂片、染色及显微镜检查





5、 凝集试验



6、 ELISA检测(酶联免疫吸附试验)


每项技能以老师示范、学生操做及综合点评等三个环节来进行。
本次训练不仅让学生学到了实验室检验岗位所需技能,更重要的是引导学生树立“做什么像什么”“干一行精一行”的信念,为毕业后零距离衔接岗位奠定扎实基础。
三、 趁热打铁,及时总结
专项训练结束后指导老师对所带班级学生进行技能考试,进一步巩固各项技能的操作要点及注意事项,并布置撰写实习报告,参与优秀实习生、优秀实验报告评比活动。
2021年12月20日陈学风主任召集所有参与实验室检验岗位专项训练的所有班级班主任及指导老师,评定出优秀实习生及优秀实习报告,决定在本年度表彰大会上进行表彰,以资鼓励。


天下难事,必作于易;天下大事,必作于细。或许,不是人人都能凭借一技之长而名闻天下,但只要不断锤炼一技之长,每个人都能奏出自己职业生涯的华彩乐章!